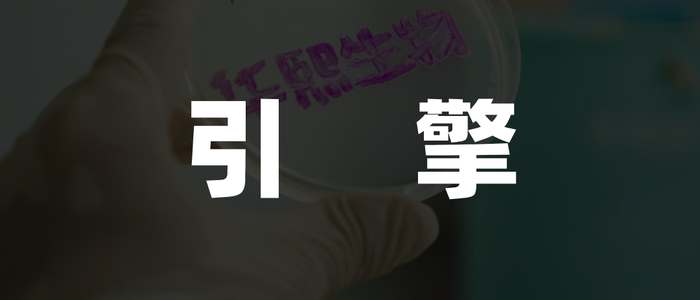

来源:新熵

华熙生物想要跨越深水区,在肃清内部管理、抢占医美市场份额之余,还需继续寻找新的增长引擎。
上市公司半年报披露季已经结束,然而外界对美妆行业上半年表现的讨论仍甚嚣尘上。
尤其对于曾头顶“玻尿酸第一股”光环的华熙生物来说,正处于发展高峰过后的阵痛期,股价自2021年达到307元的高点之后回落至46元上下,市值蒸发超1200亿元。
辉煌过后,华熙生物跌下神坛的种子或许早已在其成长历程中悄然埋藏。
01
华熙生物业绩拉垮

近年来,由于国货美妆品牌的消费者群体日益庞大,此前一度占据八成市场份额的国际大牌美妆在国内开始显出颓势。
雅诗兰黛截至2024年6月30日的2024财年业绩报告显示,亚太地区净销售额下降3%,主要受累于中国大陆市场。其中,今年二季度,海南美妆市场的零售额下降了40%以上。
2024年4月-6月,受制于市场环境的疲软,尤其是6.18这样重要促销节点的弱化,宝洁在中国的有机销售额下滑9%。甚至其一度风靡国内的明星产品SK-II也频现撤柜传闻。
此外,上半年以超1700亿元的全球销售额登顶国际美妆品牌销售额首位的欧莱雅也称,在中国大陆由于消费者信心持续低迷,美容市场在第二季度出现负增长。
尽管在销售额上同国际品牌差距尚大,但国货美妆品牌正以较快的增速占据国内市场份额。近10年来,国货美妆市场规模从2014年的1318亿元增长至2023年的4018亿元,年均复合增长率高达13.18%;除2014年、2019年外,其余年份增长率均超10%。2023年,国货美妆市场规模增速达到21.2%。

《2023年中国化妆品年鉴》数据显示,2023年中国化妆品销售额同比增长21.2%,市场份额达50.4%,首次超过国际化妆品品牌。国内外品牌此消彼长下,是消费降级、国潮兴起大趋势下消费者心智的变迁。
据统计,12家国货美妆上市公司上半年的总营收为290.24亿元,相比于2023年同期的256.47亿元,同比增长13.17%。其中,珀莱雅以50.01亿元的营收跃居榜首,上美股份借韩束发力,营收增速超100%。
与之相比,一直以来作为国货护肤品领域头部品牌的华熙生物,上半年业绩表现却难言理想。
财报显示,华熙生物上半年实现营收28.1亿元,同比下降了8.61%;实现净利润3.42亿元,同比下降了19.51%。这是华熙生物继2023年财报后的又一次营利双降。2023年,公司营收和净利润分别同比下滑4.45%和38.97%。
与华熙生物同样以功能性护肤品起家的贝泰妮,上半年实现营业收入28.05亿元,同比增长18.45%;归属于上市公司股东的净利润为4.84亿元,同比增长7.50%。此外,扣除非经常性损益的净利润也达到了4.20亿元,同比增长12.29%。
对于经营成果承压的原因,华熙生物解释称,主要在于管理变革在短期内产生的一系列费用,影响了短期损益。
其中,公司功能性护肤品业务正处于管理变革深水区,主要精力放在调整团队、梳理内部、检讨策略、纠正动作等方面,经营措施有所收紧,市场拓展未能完全展开。报告期内,华熙生物功能性护肤品业务实现收入13.81亿元,同比下降29.74%。
02
第二增长曲线难寻

21世纪初,华熙生物首席科学家郭学平带领团队以微生物发酵法、酶切法代替传统动物提取法生产玻尿酸,从而实现了玻尿酸量产。2007年,华熙生物成为全球最大的玻尿酸研发、生产和销售企业,也带动了中国玻尿酸产业的崛起。
2008年,华熙生物由toB业务转变,开始发力C端市场。2012年,华熙生物“润百颜注射用修饰透明质酸钠凝胶”成为国内第一个拿到合法批文的交联透明质酸软组织填充剂。此后,华熙生物在眼科和骨科领域的医疗终端产品,也相继拿到了上市批文。
以玻尿酸起家,功能性护肤品一直以来都是华熙生物的支柱产业。2022年,公司功能性护肤品销售额达46.07亿元,在公司营收中的占比超七成。
但随着护肤品中可添加的活性物种类越来越多,华熙生物辛苦搭建的护城河正在被瓜分。
一方面,含有玻尿酸成分的品牌鳞次栉比。从基础护肤到高端护肤,从国际品牌到国货品牌,欧莱雅、韩束、AHC、理肤泉、百雀羚等品牌相继推出含有玻尿酸成分的精华液、面膜、水乳套装等,价格也在内卷中不断下降。
以玻尿酸面膜为例,新熵查询天猫旗舰店发现,华熙生物旗下品牌润百颜单片面膜的价格为19.8元,夸迪单片玻尿酸面膜的价格最低约为16.9元。
与之相比,薇诺娜玻尿酸面膜单片价格折合7.7元,韩束玻尿酸面膜的单片价格最低打到了约3元一片,百雀羚推出的平价面膜单片价格约为2.8元。国际品牌中欧莱雅的玻尿酸面膜单片价格也仅为11.9元。

由护肤品界的“茅台”转至平价,华熙生物由玻尿酸建起的价格壁垒在内卷中轰然倒塌。
另一方面,其他活性物护肤品加入混战,玻尿酸早已不是护肤品界唯一的宠儿。在主打抗衰、美白等功效的A醇、烟酰胺、多肽、角烷鲨等成分面前,以补水嫩肤功效出圈的玻尿酸已经不是消费者的唯一选择。
当然,华熙生物并非不懂“流水不腐,户枢不蠹”的道理,近年来一直没有停下寻找第二增长曲线的脚步。不论是做肉毒素生意,还是布局胶原蛋白赛道,华熙生物都未能再现旧日辉煌。
2015年,华熙生物与韩国肉毒素企业Medytox签署了合资协议,但随着Medytox因材料造假等行为暴雷,华熙生物对肉毒素的布局也以2023年宣布与Medytox终止合作而结束。
2022年8月,华熙生物发布了包括动物源胶原蛋白、重组人源胶原蛋白、水解胶原蛋白(肽)在内的三款胶原蛋白产品,2024年5月,华熙生物召开以“胶原蛋白2.0时代”为主题的发布会并推出相关产品。
在胶原蛋白赛道上的布局还正在进行中,但与巨子生物、锦波生物凭先发优势已经站稳脚跟的企业相比,华熙生物布局胶原蛋白领域优势并不明显。创始人赵燕在2023年的一次媒体沟通会上称“对胶原蛋白持保留谨慎态度,在护肤品上只是一个补充”,似乎也揭示着胶原蛋白难以扛起公司第二增长曲线的大梁。
03
医美能成新引擎吗?
在功能性护肤品赛道中尚未找到增长引擎的华熙生物,医疗终端特别是医美领域的发展态势却是一片向好。
华熙生物上半年在医疗终端业务上实现的收入为7.43亿元,同比增长51.92%,占公司主营业务收入26.51%。其中,公司上半年皮肤类医疗产品实现收入5.55亿元,同比增长70.14%。
究其原因,还在于国内消费者对于医美产业的消费意愿不断提升。2018年至2023年,中国医疗美容行业市场规模从1217亿元增长到2666亿元,年复合增长率为16.98%。沙利文报告预测,2024年预计中国医美市场规模达3093亿元。
而由于非手术、操作简单、恢复快等优势加持,轻医美正成为医美领域中更受欢迎的细分赛道。相关报告显示,2022年中国医美手术收入占比48%,非手术收入占比52%。华熙生物旗下医美品牌润致于2020年推出名为微交联润致娃娃针的水光针,2024年上半年,该产品收入同比增长超过200%。

尽管医美业务增长势头强劲,但占比相较功能性护肤品体量尚小。不排除医美行业监管趋严使其受益,但爱美客与昊海生科等竞争者们的存在,华熙生物医美业务发展后势尚需观望。
在产品之外,华熙生物内部管理也广为诟病。无论是与夸迪前主理人枝繁繁之间的恩怨,还是创始人低价收购员工股份的丑闻,抑或是核心技术人员出走,都反映出华熙生物在内部管理方面还有许多功课要做。
值得一提的是,华熙生物一向重视研发,上半年研发人员数量继续增长。然而研发人员增加的同时,却面临核心技术人员流失的问题。这种看似矛盾的人事变动,虽然有可能为公司带来新的发展动力,但无疑也给华熙生物的研发前路增添了不确定性。
处于改革阵痛期的华熙生物,面临着双重挑战:一面需要肃清内部管理,另一方面则需在医美市场争得一席之地。在开拓医美、功能性食品等新赛道的同时,继续寻找新的增长引擎也是公司发展的必要选择。
谁能成为华熙生物跨越深水区的主要抓手?一切还是未知数。
特别声明:以上内容仅代表作者本人的观点或立场,不代表新浪财经头条的观点或立场。如因作品内容、版权或其他问题需要与新浪财经头条联系的,请于上述内容发布后的30天内进行。


